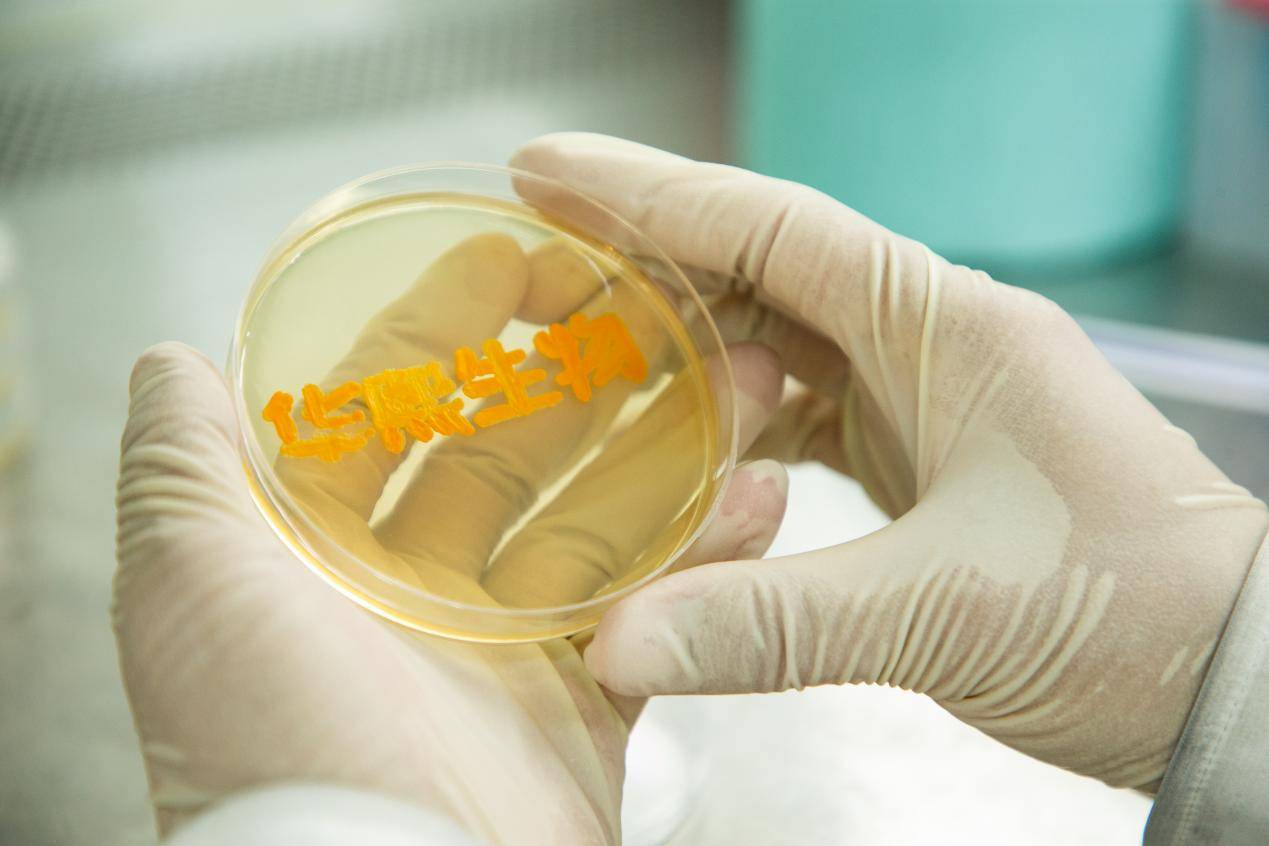
华熙生物荣获“ESG治理金牛奖””

中证报中证网讯(记者 张鹏飞)11月26日,以“治善致远 绿动未来”为主题的2025年金牛企业可持续发展论坛暨第三届国新杯·ESG金牛奖颁奖典礼在江苏苏州举行。本次大会由中国证券报、中国国新控股有限责任公司主办,国新证券承办,苏州工业园区城市发展研究院全面战略支持。备受瞩目的ESG金牛奖榜单揭晓,华熙生物荣获“ESG治理金牛奖”。

图片来源于网络,如有侵权,请联系删除
华熙生物荣获“ESG治理金牛奖”(图片来源:中国证券报)
图片来源于网络,如有侵权,请联系删除
ESG金牛奖是中国证券报针对企业ESG表现开展的评价评奖品牌。第三届国新杯·ESG金牛奖延续了金牛奖系列评选“公开、公平、公正”的核心原则,以更严谨、更科学的评价体系,筛选资本市场ESG实践的“领跑者”,激励更多企业投身可持续发展浪潮。本届ESG金牛奖共设置“ESG金牛奖百强”“ESG卓越央企金牛奖”“ESG碳中和金牛奖”“ESG科技引领金牛奖”“ESG治理金牛奖”“ESG乡村振兴金牛奖”及“ESG新锐金牛奖”七大奖项。
在行业遴选和奖项设置方面,评审委员会充分借鉴中国国新ESG评价方法论与国资委研究中心课题成果,从财务重要性与影响重要性两大维度出发,综合中国证券报ESG风险事件评估、舆情评估,以及ESG披露质量,对企业ESG表现进行系统评估。同时遵循“分类评选、覆盖多元、避免重复”原则,设置综合类奖项与分项奖项,充分衡量受评对象的ESG表现,并结合评审委员会专家的综合判断和递补原则确定获奖名单。
转载请注明:财智纵横 » 企业新讯 » 华熙生物荣获“ESG治理金牛奖””
版权声明
本文仅代表作者观点,不代表B5编程立场。
本文系作者授权发表,未经许可,不得转载。










